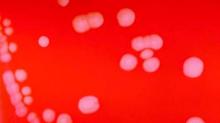

Four years ago, when meningitis B, an extremely rare but potentially lethal form of the infection, sickened a small number of college students at Princeton and the University of California–Santa Barbara, there was no vaccine against the disease sold in the U.S. Despite its availability abroad, it had never been licensed in the country due to its limited marketability.
Scientific evidence supporting an absolute need to immunize against meningitis B still falls short. The risk of contracting it is smaller than that of being involved in a car crash.
But the headlines prompted by those 13 campus cases – which resulted in one death and one double amputation – helped reshape the financial prospects for a vaccine.
Today, two brand-name vaccines, both with price tags of more than $300, are widely advertised on television and touted as a smart investment for parents who love their college-bound kids.
“As moms, we send our kids out into the world, full of hope,” says a mother in the ad for Bexsero, sold by pharmaceutical giant GlaxoSmithKline, as her son loads up the car to go off to college.
Says another voice, “And we don’t want something like meningitis B getting in their way.”
Analysts expect the two vaccines to generate annually at least hundreds of millions of dollars in global sales.
As new crops of students head to college, some physicians and other industry experts, though, are growing uneasy about the role of marketing in leveraging parental fears to sell the MenB vaccine – as well as ever more expensive vaccines that prevent quite rare illnesses. A complete Bexsero series costs $320; a competing vaccine, Trumenba, costs $345.
“Parents believe their children are susceptible to this terrible condition, and [drugmakers] use that fear to get parents to take action,” said Adrienne Faerber, a lecturer at the Dartmouth Institute for Health Policy and Clinical Practice who researches drug marketing.
The advertising, especially when coupled with news coverage, puts parents in a quandary left unresolved by federal vaccination guidelines and university requirements.
The Centers for Disease Control and Prevention recommends doctors consider the meningitis B vaccine for people ages 16-23 years on an individual basis. This recommendation – ranked as a category B – is not as universal as the approach applied to illnesses such as measles or human papillomavirus vaccines or even the “quadrivalent” vaccine for meningitis A, C, W, and Y, which all students must get.
Meanwhile, insurers generally cover it as part of preventive care. Still, most universities don’t require the vaccine but simply list it as an option for families to consider.
The resulting messages can confuse parents.
“There is perhaps, with all the marketing and advertising, some bending of the truth, and perhaps a little bit of creating fear – again recognizing that meningitis disease is a very severe disease,” said William Moss, a professor at Johns Hopkins Bloomberg School of Public Health who specializes in vaccines and global children’s health. “[The risk] is not a large enough problem to warrant routine vaccination.”
In recent years, drugmakers’ interests have begun to expand beyond the relatively cheap, broadly used immunizations – such as a tetanus shot or the children’s hepatitis A vaccine – to new, much pricier ones for less common infections.
These newer treatments have the potential to transform what’s long been a less lucrative side of drug production, manufacturing vaccines, into a major cash cow. But since the newer vaccines are regarded as less crucial than, say, preventing measles – and are often not required – marketing has become a big part of the sales equation.
Bexsero and its competitor, Trumenba, offer clues into how this scenario plays out.
Both vaccines got accelerated approval by the Food and Drug Administration in 2015 and 2014 respectively, following the Princeton and UCSB outbreaks.
Meningitis B does not spread readily from person to person. It requires close physical contact, like kissing or sharing utensils. It can be fatal but is treatable with antibiotics if caught early. Caused by the B serogroup of the meningococcal infection, it tends to appear in rare-scatter, slowed, self-limited outbreaks on college campuses. The standard meningitis vaccine doesn’t prevent it.
After new cases at Princeton and UC Santa Barbara kept appearing over many months, the CDC arranged for an emergency import of Bexsero. All students on those campuses got the shots, and there were no more cases.
Now the drugmakers are urging all parents to be proactive. Last year, Pfizer put more than $21 million into paid advertisements for the vaccine, according to figures kept by Kantar Media, a firm that tracks multimedia advertising. GlaxoSmithKline put in just about $79,000.
Those figures don’t account for other efforts such as meningitis awareness and ongoing social media campaigns done by GlaxoSmithKline, a “substantial effort” that “wasn’t cheap,” said Sriram Jambunathan, who heads GlaxoSmithKline’s meningococcal franchise in the United States. They also don’t include Pfizer’s investments in similar activities.
Already, industry analysts forecast Bexsero could bring in global revenue north of $1 billion per year by 2022. Trumenba is expected to earn Pfizer $880 million by that time.
But the industry’s gain may come at the expense of efficient health care spending and inflated consumer concern.
First, there’s the relative rarity of meningitis B. The CDC has estimated fewer than 300 cases occur in the United States per year, and some medical experts interviewed suggested the number may be closer to 50 or 60.
“As a mom, I would say, if my kid got this disease, and I had had the opportunity to prevent it, and I didn’t, I would kill myself,” said Martha Arden, a practicing physician and the medical director of Mount Sinai Adolescent Health Center’s school-based health program in New York City. “But the odds are small. It’s much more dangerous to send a kid out skiing than it is to not give the vaccine.”
Jambunathan said the price tag is warranted given the resources needed to bring Bexsero to market. Similar vaccines, he added, are comparably priced, and firms won’t necessarily want to develop these pharmaceuticals if they aren’t sure they can recoup their investment.
For parents who opt for the vaccines, there are caveats. Researchers don’t know, for instance, how long its immunity lasts. Many noted it also doesn’t cover all strains of the infection, so its efficacy in the United States is uncertain (there are different strains in different parts of the world).
And the cost of vaccination, while substantial, isn’t immediately felt by consumers because the treatment usually is covered without having to pay out-of-pocket. But the price tag may contribute to increasing premium costs.
In a world where there already aren’t enough health care dollars to address every possible harm, many experts noted, other health concerns might be a smarter investment.
Still, the price tag might not cause parents to blink. “When it’s your child or one case you know about, suddenly the health economic arguments feel difficult to have,” Jambunathan said.